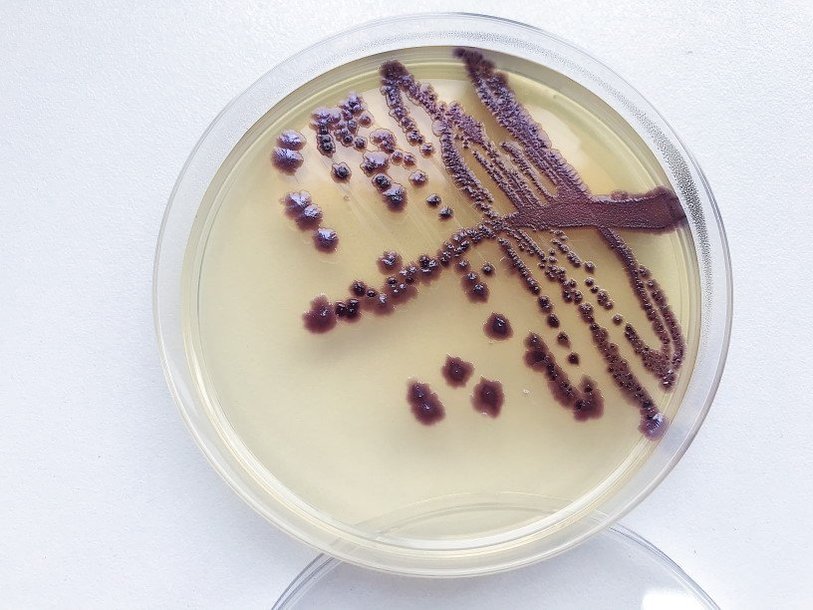

Екатерина Беленко: Промикробы: Инфекция наносит ответный удар
Фото: Екатерина Беленко
Фото: Екатерина Беленко Продолжаем разбираться с последствиями вторжения микробиков в наши макроорганизмы. Давайте поговорим о периодах инфекционной болезни.
1. Инкубационный период (кстати, это от латинского «высиживание птенцов») — от момента заражения до первых клинических признаков. В этот период возбудитель размножается, происходит накопление как возбудителя, так и выделяемых им токсинов до определенной пороговой величины, за которой организм начинает отвечать клинически выраженными реакциями. Продолжительность инкубационного периода может варьироваться от нескольких часов и суток до нескольких лет!
2. Продромальный период характеризуется общими неспецифическими проявлениями — недомоганием, головной болью, повышением температуры и другими симптомами, которые не несут признаков конкретной инфекции. Его продолжительность не превышает 24–48 часов.
3. Период развития болезни характеризуется специфическими для данной инфекции клиническими проявлениями.
4. Период реконвалесценции или выздоровления. В качестве исхода болезни может наступить выздоровление, развиться носительство или летальный исход. Период окончательного удаления инфекционного агента может затягиваться и для некоторых инфекций (например, сыпного тифа) исчисляться десятилетиями.
⠀
Инфекционное заболевание возникает не при каждом попадании патогенного микроорганизма в организм человека. Требуются определенные условия для развития болезни:
– Достаточная доза микроорганизмов. Для разных микробиков и разных болезней эта доза тоже отличается. Для чумы достаточно нескольких бактериальных клеток, для развития дизентерии — десятки, а для некоторых возбудителей — тысячи и даже сотни тысяч микробных клеток.
– Естественный путь проникновения. Существует понятие о входных воротах инфекции, различных для разных групп инфекций — раневых, респираторных, кишечных, урогенитальных и так далее. Одному микроагрессору требуется, чтобы его проглотили, а другому — чтобы вдохнули. Попав в организм через несвойственные «ворота», многие бактерии не смогут найти путь к заветной цели, а значит, и навредить своему временному хозяину тоже не смогут.
– Характеристики возбудителя, его болезнетворные свойства, способность преодолевать защитные механизмы хозяина.
– Состояние организма хозяина. Тут может сыграть роль и пол, и возраст, и наследственность, и образ жизни, и многое другое.
⠀
Существует шесть основных механизмов и путей передачи возбудителя инфекции:
• Аэрогенный. Он же воздушно-капельный, его мы все знаем: через кашель, чихание и последующее вдыхание.
• Контактный. Думаю, тоже понятный механизм: возбудитель на коже или слизистых, при контакте с восприимчивым человеком — вуаля. Бывает прямой и опосредованный — через различные предметы.
• Трансмиссивный. Тут микробикам помогают насекомые, которые делают кусь человеку.
• Фекально-оральный. Возбудитель инфекции живет в кишечнике, выходит тем или иным способом (иным — это со рвотой) в окружающую среду. Проникновение в восприимчивый организм новой жертвы происходит через рот, при заглатывании загрязненной воды, пищи, при еде с грязными руками, после чего он вновь локализуется в пищеварительном тракте.
• Вертикальный — от матери к плоду.
• Гемоконтактный. Вы сами догадались, что это про контакт с кровью. Этот самый контакт может быть естественным и искусственным — связанным с медицинскими манипуляциями, татуировками и так далее.
И снова продолжение следует. А вы пока мойте руки перед едой.